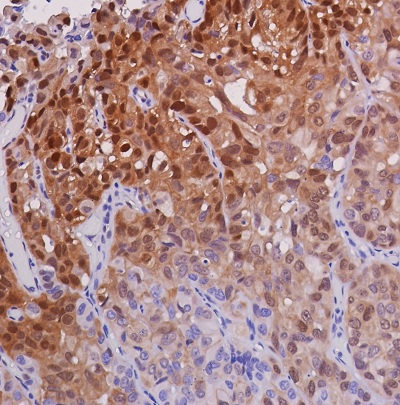
Anti-ERK1 (phospho T202 + Y204) + ERK2 (phospho T185 + Y187

マイストア
変更
お店で受け取る
(送料無料)
配送する
納期目安:
2025.11.29 11:23頃のお届け予定です。
決済方法が、クレジット、代金引換の場合に限ります。その他の決済方法の場合はこちらをご確認ください。
※土・日・祝日の注文の場合や在庫状況によって、商品のお届けにお時間をいただく場合がございます。
小物 rhsyk2 3D6dot112_A488_CD169_Antibody_の詳細情報
3D6dot112_A488_CD169_Antibody_。APC anti-mouse CD169 Siglec-1 Antibody anti-CD169 - 3D6.112。ZSK型2軸押出機 – Coperion。◾️商品情報ブランド名:PRADA プラダ商品名:長財布- その他特徴 -メンズ レディース ユニセックス ロゴ型押しラウンドファスナー 多収納◾️サイズタテ:約10.5cmヨコ:約20cmマチ:約2cm札入れ×1小銭入れ×1カードポケット×12※平置き実寸でございます※着画依頼はご遠慮お願います※ギャランティ、ケアカード、袋箱などは特記がない場合は付属しておりません。Anti-AMPK alpha 1 (phospho Thr183) + AMPK alpha 2 (phospho。◾️カラーブラック 黒◾️素材サフィアーノレザー◾️発送簡易包装にて1~2日程度で発送致します。美品【GUCCI】長財布 アニマリエ ビー レザー メタル ラウンドファスナー。仕事の都合で遅れる場合がございますので予めご了承ください。ROCADO社 シェルコードバン ロングウォレット ライトブラウン 未使用品。◾️購入元一般社団法人 日本流通自主管理協会(AACD)加盟店※大手リサイクルショップ、古物市場、業者オークション
ベストセラーランキングです
近くの売り場の商品
カスタマーレビュー
オススメ度 4.2点
現在、5252件のレビューが投稿されています。